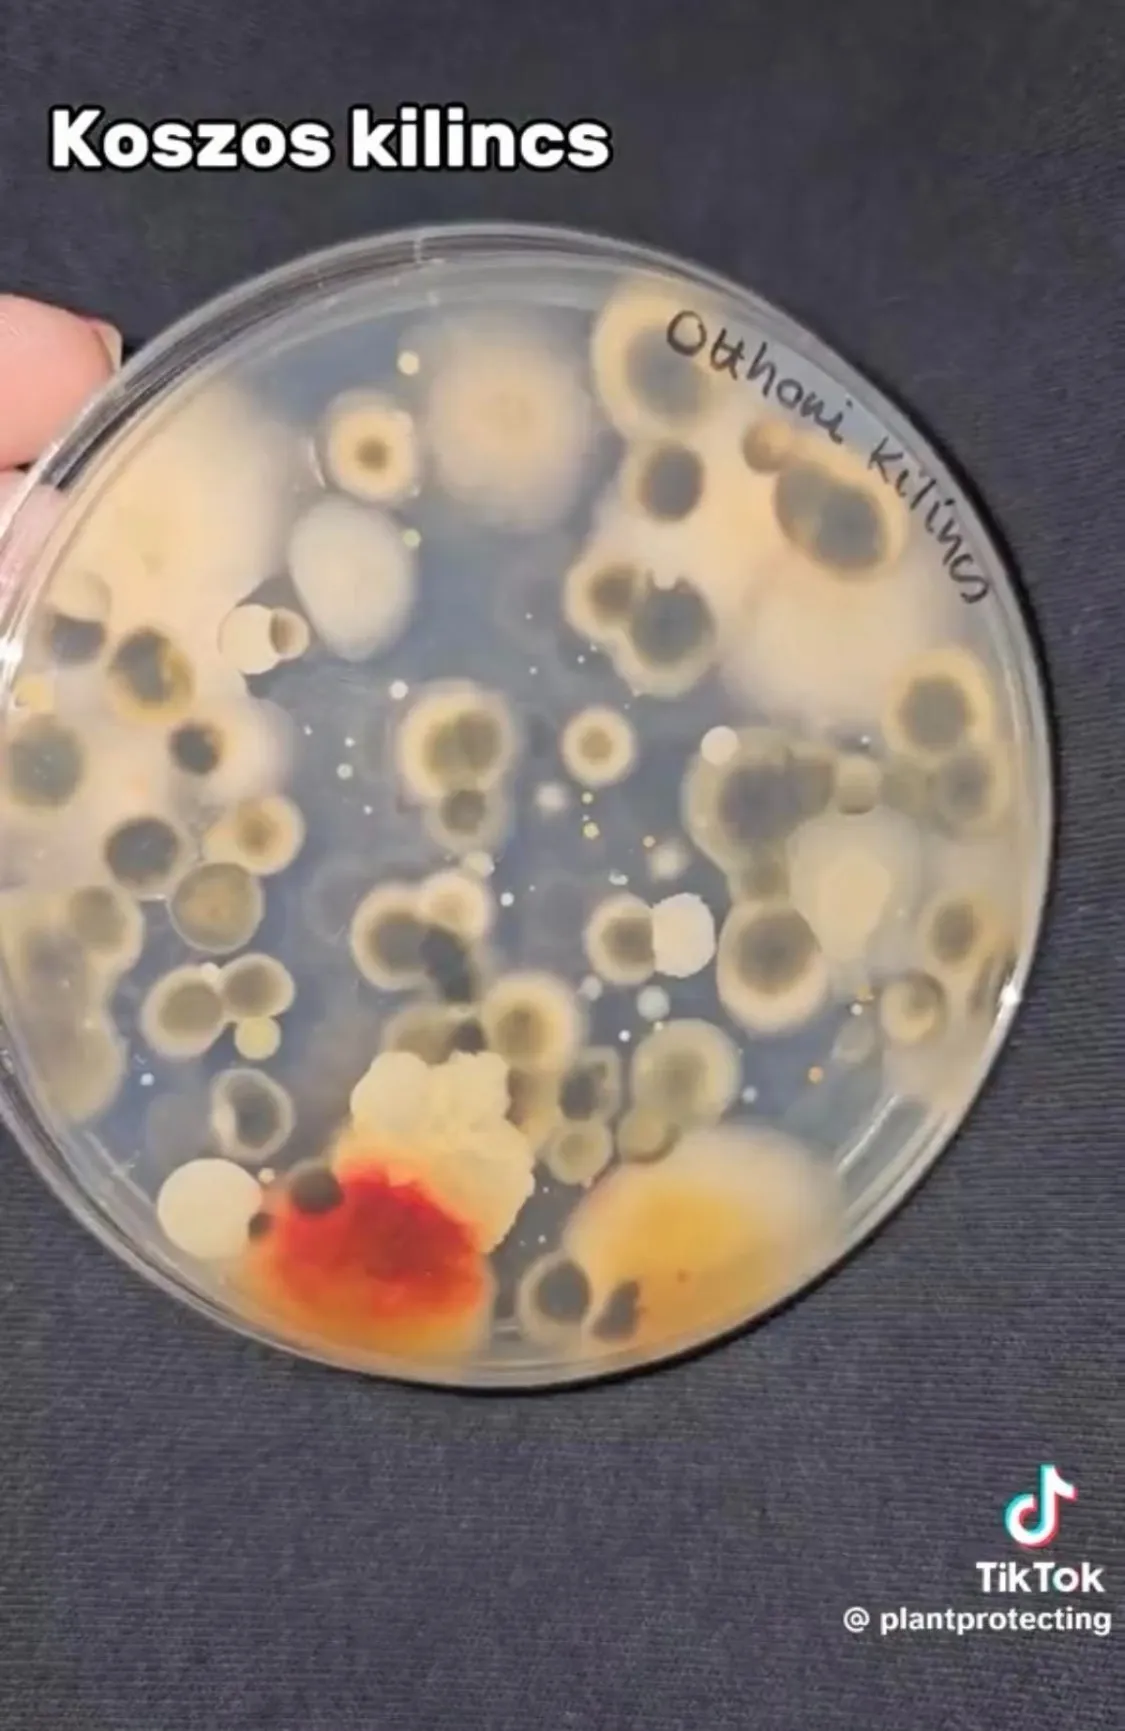

A szakember megmutatta, hogy miért fontos sűrűn takarítani a kilincseket - Videó!
A növényorvos megmutatta, hogy mennyi baci van egy kilincsen. Az eredmény megdöbbentő; ezután te is garantáltan mindennap letakarítod az ajtód kilincsét.
A TikTok kedvenc növényorvosa, Gyuris Rita legújabb kísérletében a bejárati ajtó kilincsét tesztelte le.

„Kilincsteszt következik közkívánatra, nézzük meg, hogy mennyi baktérium és gomba van a kilincseken” - kezdte TikTok-videójában a növényorvos.
A mi otthoni kilincsünkről történt a mintavétel, így volt a legegyszerűbb. Egy steril mintavevő pálcával mintát vettem és ezt utána táptalajra helyeztem. Gondoltam azért csinálok hozzá egy fertőtlenítő kontrolt is, ezért fogtam egy fertőtlenítő kendőt és áttöröltem vele az egész kilincset.
Rita a videójában hangsúlyozta a kilincs tisztításának fontosságát.
Minden ötödik magyar soha, vagy csak a beköltözéskor tisztította meg a bejárati ajtó kilincsét. Az embereknek pedig mindössze negyede törli le a kilincseket és a kapcsolókat az otthonában
- mondta. „Én a teszt előtt körülbelül egy hete takarítottam le a kilincsemet.”
„Számos baktérium kolónia és gombatelep nőtt fel”
„Már az első napra számos baktérium kolónia és gombatelep nőtt fel. Alakjukból, színükből, méretükből kifolyólag is más-más baktériumok és gombák. Az idő előrehaladtával ezek a mikroorganizmusok szaporodnak, tehát a telepek és a kolóniák növekedni kezdenek.”
„Rendszeresen tisztítsuk meg a kilincseket”
Rita a letisztított kilincséről is vett mintát.
A tisztított kilincsen egyetlen egy darab gombatelep jelent meg. A teszt szépen megmutatja, hogy mennyire fontos a takarítás és hogy milyen sok baktériumot vihetünk be egy mozdulattal a lakásba. Éppen ezért fontos, hogy rendszeresen tisztítsuk meg a kilincseket
- tanácsolja a szakember.






